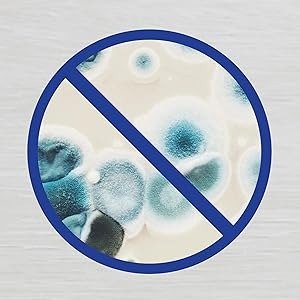
Imagen 2

DESINFECTANTE EN AEROSOL LYSOL 475 ML
- Efectivo contra el virus causante de COVID-19, incluida la Variante Delta*, así como la Influenza A H1N1.
- Desinfecta las superficies de tu hogar con Lysol Desinfectante Antibacterial para Superficies.
- Úselo en superficies y áreas de constante contacto/uso, como: botes de basura, manijas, superficies de baño y juguetes.
- Desinfecta tu hogar creando un ambiente fresco, con sensación de vitalidad y energía.

Valoraciones
No hay valoraciones aún.